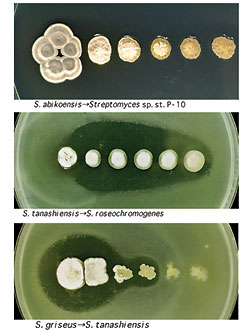

|
 |
 |
 |
 |
 |
 |
 |
上田 賢志 |
|
 |
 |
| 東京大学大学院農学生命科学研究科博士課程修了 |
| 1993年 |
日本学術振興会特別研究員 |
| 1995年 |
日本大学農獣医学部(現生物資源科学部)応用生物科学科 助手 |
| 1999年 |
日本大学生物資源科学部応用生物科学科 講師 |
| 2002年 |
日本大学生物資源科学部応用生物科学科 助教授 |
|
|
 |
 |
 |
放線菌は原核生物でありながらカビに似た複雑な形態分化を行う特徴的な微生物である(図1)。また、抗生物質をはじめとする様々な二次代謝産物を生産する産業的に重要な菌群としても知られている。放線菌の形態分化と二次代謝は遺伝的に互いに密接に関わっており、いくつかのモデル菌株を用いた分子レベルの研究は、その遺伝制御機構を詳細に解明しつつある。
放線菌における分化と二次代謝制御の特徴の一つは、菌自身が生産する菌体外拡散性の信号物質によってそれらの誘導がおこることである。ストレプトマイシン生産菌Streptomyces
griseusでは、A-ファクターと呼ばれるg-ラクトン化合物がその特異的レセプター蛋白質を介して作用し、形態分化と抗生物質生産の開始を誘導することが知られている。同族の自己調節物質による分化と二次代謝の誘導制御は、現在では様々な放線菌において見いだされている。
こうした背景において我々は、類似の誘導現象が異なる種の間においても見られることを広範な探索研究によって明らかにした。多数の保存菌株ならびに自然界分離株を対象として、異なる菌株を互いに近傍に植菌した場合に分化や抗生物質の生産が促進される組み合わせを探したところ、図2に例示されるような促進現象が非常に高い頻度(30%)で起こることが観察された。このことは、土壌を主な生存圏とする放線菌群が、種を越えて互いの分化や二次代謝を促進する集団を形成している可能性が示唆された1)。
COE研究では、この新しい生物現象を分子レベルで解明することをめざし、上記において促進現象が観察された組み合わせのうち、S.
griseusがStreptomyces tanashiensisの増殖と分化・二次代謝を誘導する現象(図2A)について、前者が生産する促進物質の単離精製を行った。S.
griseusの液体培養上清から陰イオン交換、ゲル濾過および逆相クロマトグラフィーを用いて得られた精製画分についてNMRおよびMSによる構造解析を行った結果、促進物質はDesferrioxamine
Eとして知られる放線菌が生産するシデロフォアの一種であった(図3)。
シデロフォアは鉄イオンを包摂して細胞内へ輸送する担体として知られる化合物である。そこで、シデロフォアとして知られる一連の化合物群を調べたところ、Desferrioxamine
Eの類縁体に同様の活性が認められたが、その他の化合物には活性はみられなかった。また、鉄イオンそのものにもS.
tanashiensisの増殖促進活性はなかった。さらに、Desferrioxamine EはS.
tanashiensis以外の様々な放線菌の増殖や分化および二次代謝を促進する活性があること、また逆に様々なS.
griseus株が同様の活性を示す物質を生産することも明らかになった。それは冒頭で触れたA-ファクターによる制御機構が遺伝的に詳しく調べられているS.
griseusについても同様であった。
そこで次に、A-ファクターによる信号伝達に主要に関与する制御遺伝子群の破壊株についてS. tanashiensisの増殖促進活性を調べたところ、いずれもその活性を失っていることが判明した。このことから、他の二次代謝産物の合成と同様にDesferrioxamine
Eもしくはその類縁化合物の生産はA-ファクターによって制御されていることが強く示唆され、自己調節因子による制御の下流で種を越えた相互作用に活性を示す化合物の合成がなされるという一つの図式が浮上した。
我々はさらに、ゲノム情報を利用してStreptomyces coelicolor A3(2)のDesferrioxamine
E生合成遺伝子クラスターを特定してその遺伝子破壊株を作成することで、その遺伝子クラスターがS.
tanashiensisの増殖を促進する物質の生産に直接関与することを明らかにした。今後同様の実験をS.
griseusにおいても行い、さらにその発現制御機構を詳細に調べることで、自己調節から種間相互作用に至る一連の信号伝達系を解明できると考える。さらに、放線菌が生産するシデロフォアの環境における動態とその役割に関する新しい知見が分子生態学的な手法によって得られるものと期待している。
|
 |
| 図1. 放線菌
Streptomyces griseusの生活環 |
|
|
| 図2. |
異なる放線菌種の間における
分化・二次代謝の促進現象例 |
|
|
 |
| 図3. Desferrioxamine
E の構造 |
|
|
|
 |
 |
 |
| 1 |
| Ueda, K, Kawai, S, Ogawa, H, Kiyama, A,
Kubota, T, Kawanobe, H and Beppu, T. Wide
distribution of interspecific stimulatory
events on antibiotic production and sporulation
among Streptomyces species. J Antibiot 53:979-82,
2001. |
|
| 2 |
| Endo, K, Hosono, K, Beppu, T and Ueda,
K. A novel extracytoplasmic phenol oxidase
of Streptomyces: its possible involvement
in the onset of morphogenesis. Microbiology
148:1767-76, 2002. |
|
| 3 |
| Ueda, K, Oinuma, K, Ikeda, G, Hosono, K,
Ohnishi, Y, Horinouchi, S and Beppu, T. AmfS,
an extracellular peptidic morphogen in Streptomyces
griseus. J Bacteriol 184:1488-92, 2002. |
|
|
|
 |
 |
 |
 |
| Copyright 2005 Nihon University
All Rights Reserved. |
|
|
|